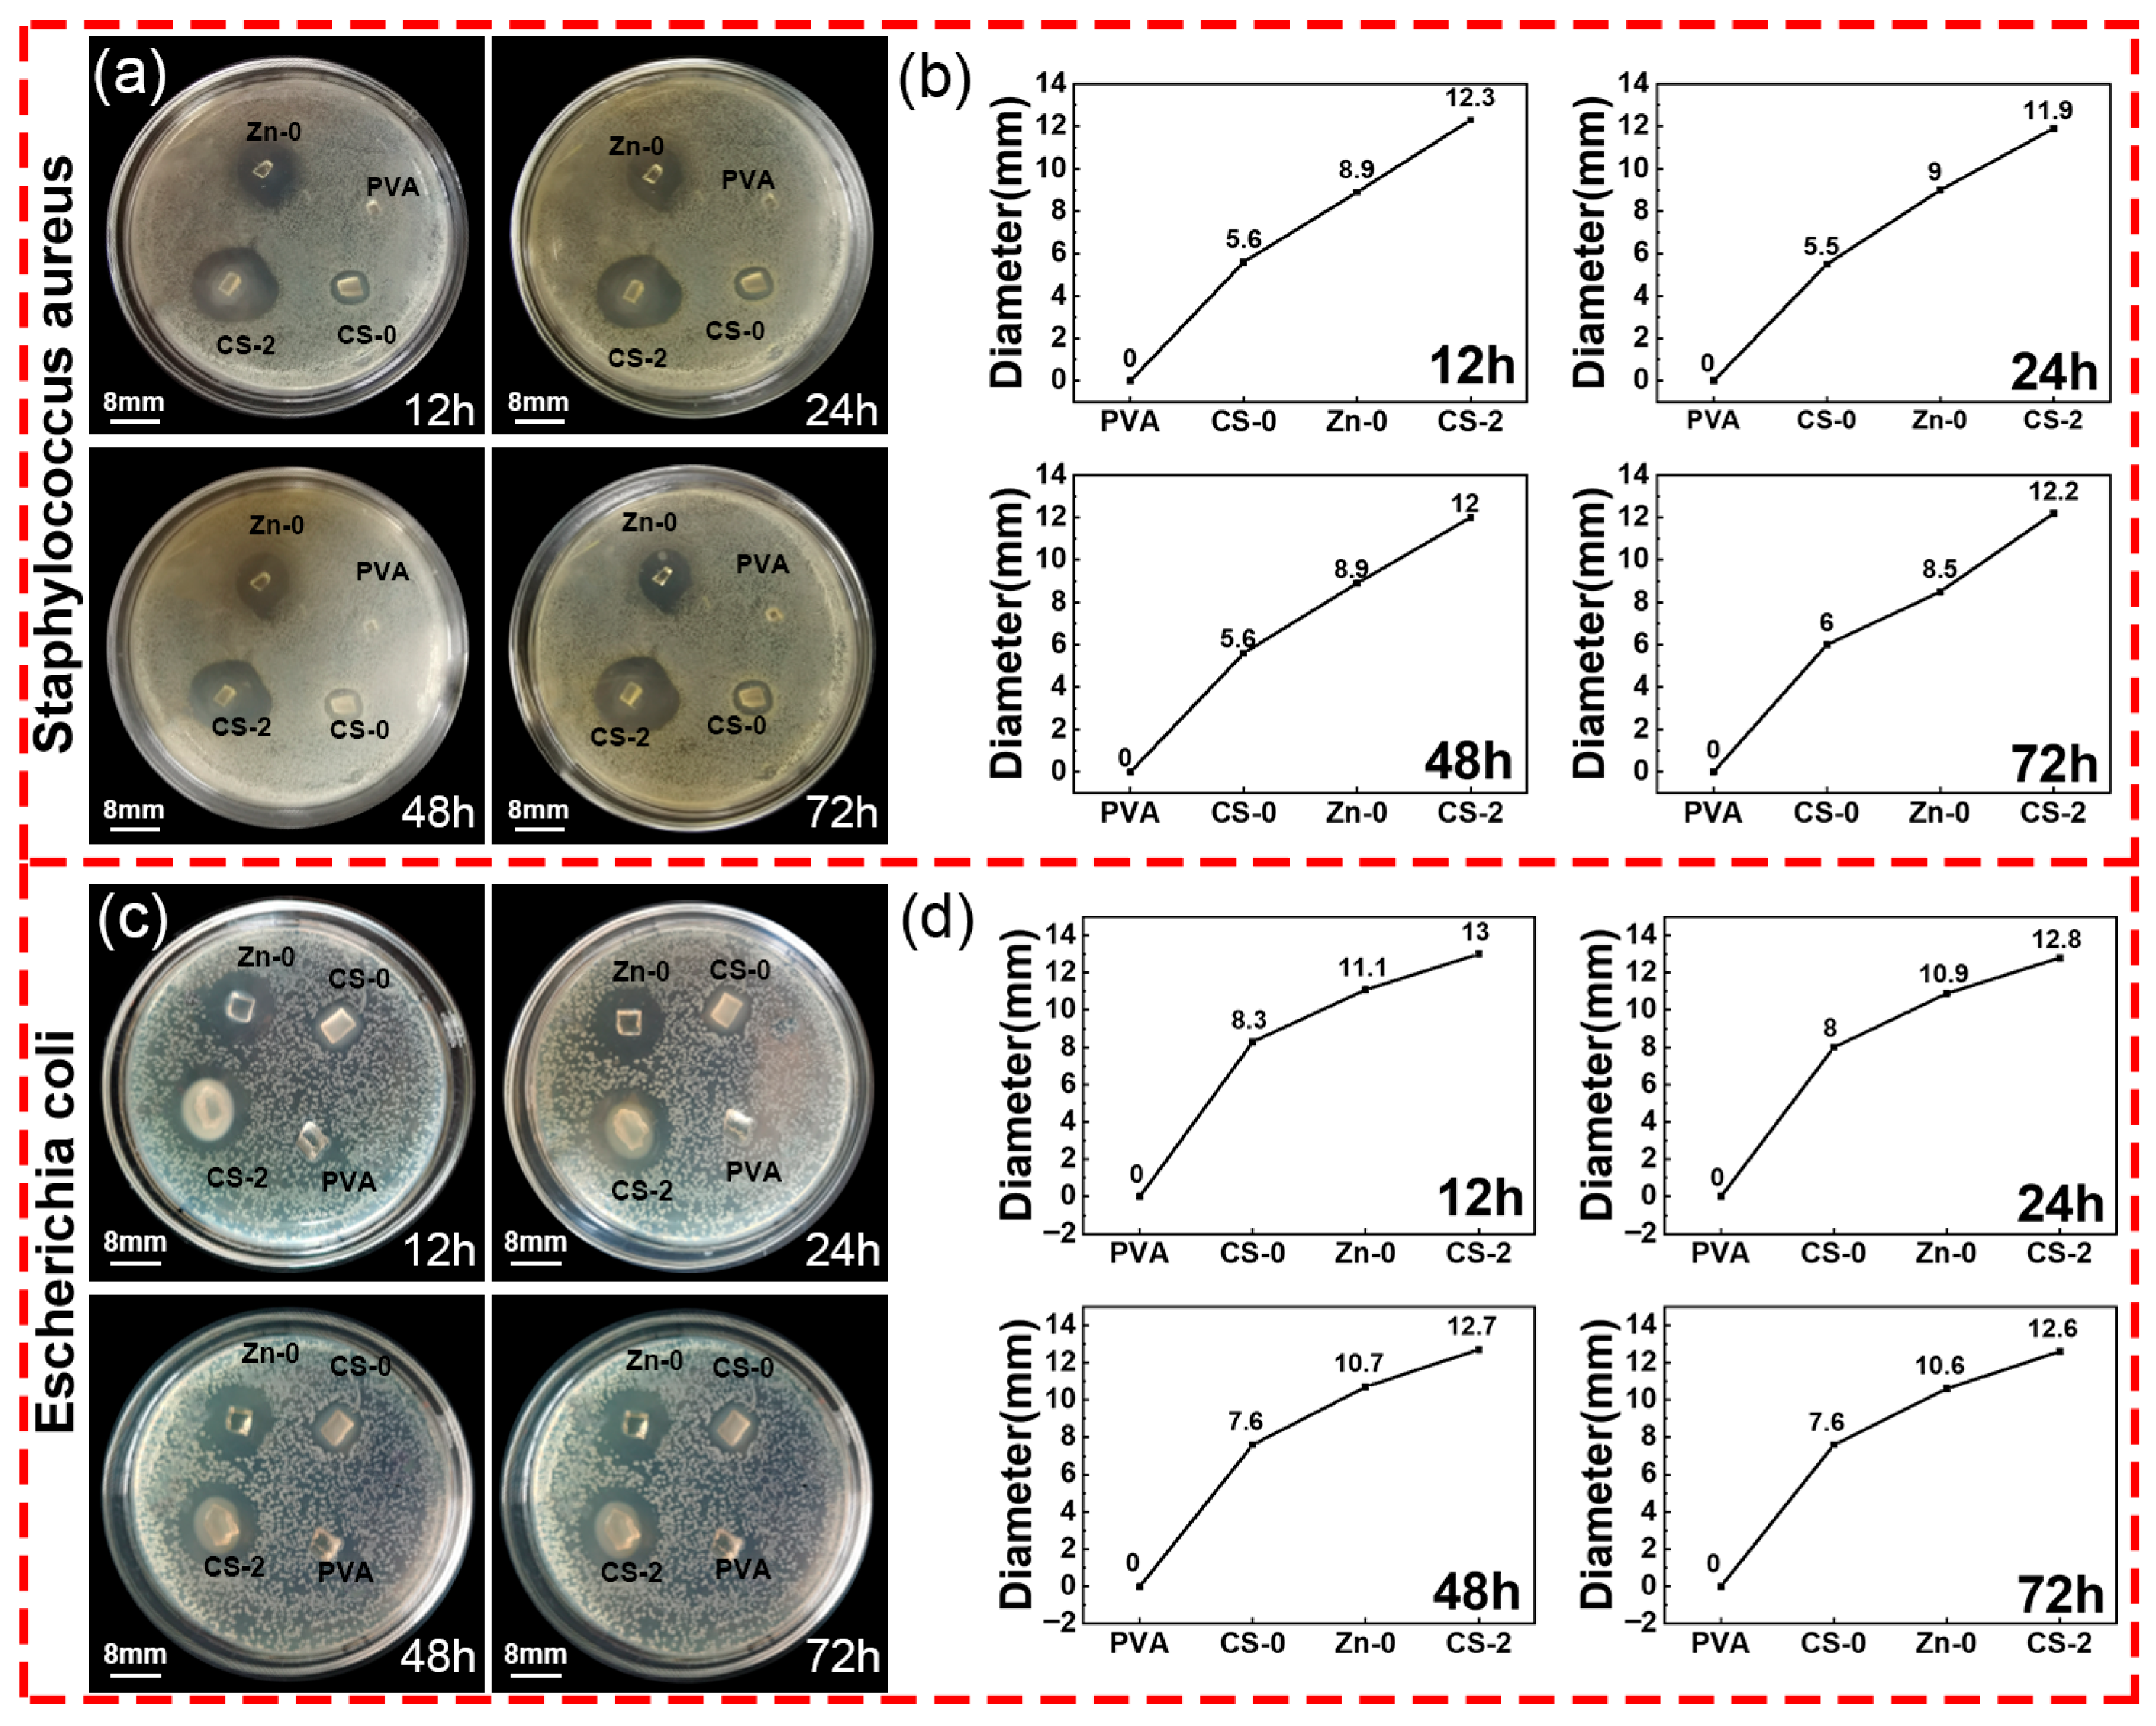
Polymers 17 03099 g010

Preparation and Characterization of Chitosan/Polyvinyl Alcohol/Zinc Gluconate Hydrogel: Antibacterial and Zinc Ion Release
Abstract
1. Introduction
2. Materials and Methods
2.1. Materials
2.2. Preparation of CS/PVA/Zinc Gluconate Hydrogel
2.3. Scanning Electron Microscopy Analysis
2.4. Fourier Transform Infrared (FT-IR) Spectroscopy
2.5. Gel Content
2.6. Water Evaporation Ratio
2.7. Swelling Ratio
2.8. In Vitro Zinc Ions Release
2.9. Antibacterial Properties
2.10. Cytotoxicity Testing
3. Results and Discussion
3.1. Morphology of Hydrogel
3.2. FT-IR Spectroscopy
3.3. Gel Content
3.4. Water Evaporation Ratio
3.5. Swelling Ratio
3.6. Release Properties of Zinc Ions
3.7. Antibacterial Activity Test
3.8. Cytotoxicity Testing
4. Conclusions
Author Contributions
Funding
Institutional Review Board Statement
Data Availability Statement
Conflicts of Interest
References
- Salarizadeh, N.; Sabour, E.S.; Hushmandi, K. Two-layered sodium alginate/polyvinyl alcohol/chitosan-based nanocomposite wound dressing with Hyssopus officinalis extract for enhanced wound healing. Ind. Crops Prod. 2025, 235, 121736. [Google Scholar] [CrossRef]
- Ghaneialvar, H.; Soltani, L.; Mami, S.; Azizian, H.; Abbasi, N.; Gholami, M.; Molaei, S.; Ghadermazi, M.; Alizadeh, R.; Akbari, A.R.; et al. Green Synthesis of ZnO and Mg-doped ZnO Nanoparticles Using Ferulago angulata Plant Extract and Its Effect on Second-Degree Burn Wound Healing. Cell Biochem. Funct. 2025, 43, e70121. [Google Scholar] [CrossRef]
- Hadisi, Z.; Farokhi, M.; Bakhsheshi-Rad, H.R.; Jahanshahi, M.; Hasanpour, S.; Pagan, E.; Dolatshahi-Pirouz, A.; Zhang, Y.S.; Kundu, S.C.; Akbari, M. Hyaluronic Acid (HA)-Based Silk Fibroin/Zinc Oxide Core-Shell Electrospun Dressing for Burn Wound Management. Macromol. Biosci. 2025, 20, 1900328. [Google Scholar] [CrossRef] [PubMed]
- Wang, J.; Zhang, C.N.; Xu, X.; Sun, T.C.; Kong, L.C.; Ning, R.D. In Situ Formation of Hydrogels Loaded with ZnO Nanoparticles Promotes Healing of Diabetic Wounds in Rats. ACS Omega 2024, 9, 51442–51452. [Google Scholar] [CrossRef]
- Mao, J.Q.; Zhang, Y.T.; Shen, T.; Zeng, Q.Y.; Zhang, W.L.; Zhang, X.Y.; Liu, Q.; Zheng, H.; Lv, G.Y. Sustained-release microneedle system based on PCL/PLA and cerium/zinc-doped bioactive glass for gastric ulcer repair. Mater. Chem. Phys. 2026, 348, 131584. [Google Scholar] [CrossRef]
- Xiao, D.; Huang, Y.Y.; Fang, Z.H.; Liu, D.Y.; Wang, Q.; Xu, Y.C.; Li, P.; Li, J. Zinc oxide nanoparticles for skin wound healing: A systematic review from the perspective of disease types. Mater. Today Bio 2025, 34, 102221. [Google Scholar] [CrossRef] [PubMed]
- Shereef, N.; Abass, M.; Tolba, E.; Ragab, W.; Rizk, A.; Karrouf, G. Antibacterial and Regenerative Potential of Zinc Oxide Nanoparticles and Carboxymethyl Cellulose for Infected Wound Healing in Rats. J. Biomed. Mater. Res. Part B–Appl. Biomater. 2025, 113, e35607. [Google Scholar] [CrossRef] [PubMed]
- Keil, C.; Hübner, C.; Richter, C.; Lier, S.; Barthel, L.; Meyer, V.; Subrahmanyam, R.; Gurikov, P.; Smirnova, I.; Haase, H. Ca-Zn-Ag Alginate Aerogels for Wound Healing Applications: Swelling Behavior in Simulated Human Body Fluids and Effect on Macrophages. Polymers 2020, 12, 2741. [Google Scholar] [CrossRef]
- Tavakoli, S.; Mokhtari, H.; Kharaziha, M.; Kermanpur, A.; Talebi, A.; Moshtaghian, J. A multifunctional nanocomposite spray dressing of Kappa-carrageenan-polydopamine modified ZnO/L-glutamic acid for diabetic wounds. Mater. Sci. Eng. C–Mater. Biol. Appl. 2020, 111, 110837. [Google Scholar] [CrossRef]
- Zhang, M.H.; Chen, S.Y.; Zhong, L.; Wang, B.X.; Wang, H.P.; Hong, F. Zn2+-loaded TOBC nanofiber-reinforced biomimetic calcium alginate hydrogel for antibacterial wound dressing. Int. J. Biol. Macromol. 2020, 143, 235–242. [Google Scholar] [CrossRef]
- Koga, A.Y.; Felix, J.C.; Silvestre, R.G.M.; Lipinski, L.C.; Carletto, B.; Kawahara, F.A.; Pereira, A.V. Evaluation of wound healing effect of alginate film containing Aloe vera gel and cross-linked with zinc chloride. ACTA Cir. Bras. 2020, 35, e202000507. [Google Scholar] [CrossRef] [PubMed]
- Dodero, A.; Scarfi, S.; Pozzolini, M.; Vicini, S.; Alloisio, M.; Castellano, M. Alginate-Based Electrospun Membranes Containing ZnO Nanoparticles as Potential Wound Healing Patches: Biological, Mechanical, and Physicochemical Characterization. ACS Appl. Mater. Interfaces 2020, 12, 3371–3381. [Google Scholar] [CrossRef]
- Rihova, M.; Azpeitia, S.; Cihalova, K.; Michalicka, J.; Chennam, P.K.; Kolibalova, E.; Svoboda, R.; Heger, Z.; Knez, M.; Macak, J.M. Centrifugally spun and ZnO-infiltrated PVA fibers with antibacterial activity for treatment of Acne vulgaris. J. Control. Release 2025, 383, 113777. [Google Scholar] [CrossRef]
- Ding, J.J.; Sun, X.Y.; Zhao, Q.L.; Liu, X.Y.; He, Q.D.; Yin, Y.; Wu, J.F.; Guo, F.; Wang, W.B. Molecular engineering of synergistic amidoxime-carboxyl dual-active sites in hydrogel for exceptional rare earth ion capture. Sep. Purif. Technol. 2025, 379, 134930. [Google Scholar] [CrossRef]
- Wang, J.F.; Ma, Y.; Meng, Q.Y.; Yang, Y.Y.; Zhang, R.T.; Zhong, S.L.; Gao, Y.; He, W.Q.; Cui, X.J. Photocrosslinked carboxymethylcellulose-based hydrogels: Synthesis, characterization for curcumin delivery and wound healing. Int. J. Biol. Macromol. 2024, 275, 133558. [Google Scholar] [CrossRef]
- Zhao, Y.; Wang, X.Y.; Qi, R.L.; Yuan, H.X. Recent Advances of Natural-Polymer-Based Hydrogels for Wound Antibacterial Therapeutics. Polymers 2023, 15, 3305. [Google Scholar] [CrossRef]
- Khan, A.; Rehman, W.; Alanazi, M.M.; Khan, Y.; Rasheed, L.; Saboor, A.; Iqbal, S. Development of Novel Multifunctional Electroactive, Self-Healing, and Tissue Adhesive Scaffold to Accelerate Cutaneous Wound Healing and Hemostatic Materials. ACS Omega 2023, 8, 39110–39134. [Google Scholar] [CrossRef]
- Sundari, M.M.; Jegatheesan, A.; Mohan, R.; Raj, M.S.A.; Devi, N.A.; Ravikumar, P.; Ayyanar, M.; Ravichandran, K. Exploring the bioactive potential of chitosan extracted from Portunus trituberculatus crab shell for multifaceted applications: Antioxidant, antidiabetic, anti-inflammatory and cytotoxic activities. Mater. Lett. 2025, 393, 138581. [Google Scholar] [CrossRef]
- Rengasamy, G.; Chinnalagu, D.K.; Chinniah, K.; Mahalingam, S. Biodegradable multifunctional fabrication of silver-doped zinc oxide nanoparticle on chitosan/polyvinyl alcohol flexible film for effective antibacterial potential and attenuation of human liver carcinoma cells. Int. J. Biol. Macromol. 2025, 321, 146309. [Google Scholar] [CrossRef] [PubMed]
- Su, Y.Y.; Li, C.Y.; Hou, Y.W.; Zhao, J.Y.; Zhao, B.Q.; Lu, Y.N.; Wang, Y.X.; Lv, C.X.; Ren, T.; Lv, S.F.; et al. Injectable hydrogel based on the furoic acid-modified chitosan for accelerating wound healing. Int. J. Biol. Macromol. 2025, 321, 146280. [Google Scholar] [CrossRef] [PubMed]
- Zhou, W.; Zhu, L.; Zu, X.R.; Ma, Y.L.; Shen, P.; Hu, Y.Y.; Zhang, P.F.; Ni, Z.X.; Wang, N.N.; Sun, D.Z.; et al. A novel antioxidant and anti-inflammatory carboxymethylcellulose/chitosan hydrogel loaded with cannabidiol promotes the healing of radiation-combined wound skin injury in the 60Co γ-irradiated mice. Phytomedicine 2025, 142, 156790. [Google Scholar] [CrossRef] [PubMed]
- Yang, S.; Lei, P.; Shan, Y.J.; Zhang, D.W. Preparation and characterization of antibacterial electrospun chitosan/poly (vinyl alcohol)/graphene oxide composite nanofibrous membrane. Appl. Surf. Sci. 2018, 435, 832–840. [Google Scholar] [CrossRef]
- Saravanabhavan, S.S.; Kamalakannan, V.P.; Thanarasu, A.; Marimuthu, N.; Devarajan, P.; Sivalinga, V.D.; Natarajan, K.; Natesan, B. A method to remove heavy metals from wastewater by modifying the surface of a PVDF membrane using chitosan and PANi and assessing it using the Hermia model. Int. J. Biol. Macromol. 2025, 316, 144673. [Google Scholar] [CrossRef]
- Sánchez-Cid, P.; Jiménez-Rosado, M.; Romero, A.; Pérez-Puyana, V. Novel Trends in Hydrogel Development for Biomedical Applications: A Review. Polymers 2022, 14, 3023. [Google Scholar] [CrossRef] [PubMed]
- Mahmoudi, C.; Douma, N.T.; Mahmoudi, H.; Iurciuc, C.E.; Popa, M.; Hamcerencu, M.; Andritoiu, C.V. Developing and Characterizing a Biocompatible Hydrogel Obtained by Cross-Linking Gelatin with Oxidized Sodium Alginate for Potential Biomedical Applications. Polymers 2024, 16, 3143. [Google Scholar] [CrossRef]
- Zhang, Y.L.; Wang, S.Y.; Tian, Y.; Chen, L.; Du, Y.H.; Su, G.H.; Hu, Y. Multi-Physically Cross-Linked Hydrogels for Flexible Sensors with High Strength and Self-Healing Properties. Polymers 2023, 15, 3748. [Google Scholar] [CrossRef]
- Xu, R.T.; He, H.P.; Deng, H.; Dong, Y.H.; Wu, X.J.; Xia, Z.N.; Zhou, Y.; Yang, L.; Huang, Z.J.; Xu, W.J.; et al. Study of conductive nerve conduits for anti-inflammatory and antioxidant effects. RSC Adv. 2025, 15, 14136–14151. [Google Scholar] [CrossRef]
- Dimic-Misic, K.; Imani, M.; Gasik, M. Effects of Hydroxyapatite Additions on Alginate Gelation Kinetics During Cross-Linking. Polymers 2025, 17, 242. [Google Scholar] [CrossRef]
- Bashir, S.; Hina, M.; Iqbal, J.; Rajpar, A.H.; Mujtaba, M.A.; Alghamdi, N.A.; Wageh, S.; Ramesh, K.; Ramesh, S. Fundamental Concepts of Hydrogels: Synthesis, Properties, and Their Applications. Polymers 2022, 12, 2702. [Google Scholar] [CrossRef]
- Moreira, R.N.F.; Chevallier, P.; Fernandez, S.R.; Viallon, M.; de Oliveira, M.X.; Soares, A.L.D.; Mantovani, D.; Feitosa, J.P.D.; Vieira, R.S. Enhanced Mechanical Properties of Injectable Chitosan-Guar Gum Hydrogel Reinforced with Bacterial Cellulose Nanofibers for Tissue Engineering Applications. Adv. Eng. Mater. 2025, 27, 2500081. [Google Scholar]
- Popescu, I.; Turtoi, M.; Su, D.M.; Dinu, M.V.; Darie-Nita, R.N.; Anghelache, M.; Calin, M.; Constantin, M. Alginate/poloxamer hydrogel obtained by thiol-acrylate photopolymerization for the alleviation of the inflammatory response of human keratinocytes. Int. J. Biol. Macromol. 2021, 180, 418–431. [Google Scholar] [CrossRef] [PubMed]
- Calina, I.; Demeter, M.; Scarisoreanu, A.; Abbas, A.; Raza, M.A. Role of Ionizing Radiation Techniques in Polymeric Hydrogel Synthesis for Tissue Engineering Applications. Gels 2025, 11, 47. [Google Scholar] [CrossRef] [PubMed]
- Yan, X.L. Infrared Spectrum Analysis of Irradiated Polyvinyl alcohol. J. Yili Norm. Univ. (Nat. Sci. Ed.) 2010, 1, 35–37. [Google Scholar]
- Ju, Y.K.; Zeng, H.X.; Ye, X.Z.; Dai, M.H.; Fang, B.R.; Liu, L.L. Zn2+ incorporated composite polysaccharide microspheres for sustained growth factor release and wound healing. Mater. Today Bio 2023, 22, 100739. [Google Scholar] [CrossRef]
- Zhou, Q.; Liu, J.; Yan, J.; Guo, Z.B.; Zhang, F.M. Magnetic microspheres mimicking certain functions of macrophages: Towards precise antibacterial potency for bone defect healing. Mater. Today Bio 2023, 20, 100651. [Google Scholar] [CrossRef]
- Xie, L.C.; Zhang, Z.C.; He, Y.C. Antibacterial Effect of Polyvinyl Alcohol/Biochar–Nano Silver/Sodium Alginate Gel Beads. Processes 2023, 11, 2330. [Google Scholar] [CrossRef]
- Farid, E.A.; Davachi, S.M.; Pezeshki-Modaress, M.; Taranejoo, S.; Seyfi, J.; Hejazi, I.; Hakim, M.T.; Najafi, F.; D’Amico, C.; Abbaspourrad, A. Preparation and characterization of polylactic-co-glycolic acid/insulin nanoparticles encapsulated in methacrylate coated gelatin with sustained release for specific medical applications. J. Biomater. Sci. Polym. Ed. 2020, 31, 910–937. [Google Scholar] [CrossRef] [PubMed]

| Name | PVA | CS-0 | CS-0.5 | CS-1 | CS-1.5 | CS-2 | CS-2.5 | CS-3 |
|---|---|---|---|---|---|---|---|---|
| CS–PVA–Zinc gluconate | 0:5:0 | 0:5:1 | 0.5:5:1 | 1:5:1 | 1.5:5:1 | 2:5:1 | 2.5:5:1 | 3:5:1 |
| Name | PVA | Zn-0 | Zn-0.5 | Zn-1 | Zn-1.5 | Zn-2 | Zn-2.5 | Zn-3 |
|---|---|---|---|---|---|---|---|---|
| CS–PVA–Zinc gluconate | 0:5:0 | 2:5:0 | 2:5:0.5 | 2:5:1 | 2:5:1.5 | 2:5:2 | 2:5:2.5 | 2:5:3 |
Disclaimer/Publisher’s Note: The statements, opinions and data contained in all publications are solely those of the individual author(s) and contributor(s) and not of MDPI and/or the editor(s). MDPI and/or the editor(s) disclaim responsibility for any injury to people or property resulting from any ideas, methods, instructions or products referred to in the content. |
© 2025 by the authors. Licensee MDPI, Basel, Switzerland. This article is an open access article distributed under the terms and conditions of the Creative Commons Attribution (CC BY) license (https://creativecommons.org/licenses/by/4.0/).
Share and Cite
Wang, Y.; Bao, Y.; Yao, Y.; Chen, S.; Tang, W.; Liu, J.; Wang, J.; Li, Z.; Tian, B.; Wu, S.; et al. Preparation and Characterization of Chitosan/Polyvinyl Alcohol/Zinc Gluconate Hydrogel: Antibacterial and Zinc Ion Release. Polymers 2025, 17, 3099. https://doi.org/10.3390/polym17233099
Wang Y, Bao Y, Yao Y, Chen S, Tang W, Liu J, Wang J, Li Z, Tian B, Wu S, et al. Preparation and Characterization of Chitosan/Polyvinyl Alcohol/Zinc Gluconate Hydrogel: Antibacterial and Zinc Ion Release. Polymers. 2025; 17(23):3099. https://doi.org/10.3390/polym17233099
Chicago/Turabian StyleWang, Yujia, Yanling Bao, Yongtao Yao, Sijia Chen, Wenpeng Tang, Jiawen Liu, Juncheng Wang, Zhigang Li, Bo Tian, Shibo Wu, and et al. 2025. "Preparation and Characterization of Chitosan/Polyvinyl Alcohol/Zinc Gluconate Hydrogel: Antibacterial and Zinc Ion Release" Polymers 17, no. 23: 3099. https://doi.org/10.3390/polym17233099
APA StyleWang, Y., Bao, Y., Yao, Y., Chen, S., Tang, W., Liu, J., Wang, J., Li, Z., Tian, B., Wu, S., Zhao, H., Huo, P., Dong, J., & Zhang, D. (2025). Preparation and Characterization of Chitosan/Polyvinyl Alcohol/Zinc Gluconate Hydrogel: Antibacterial and Zinc Ion Release. Polymers, 17(23), 3099. https://doi.org/10.3390/polym17233099

